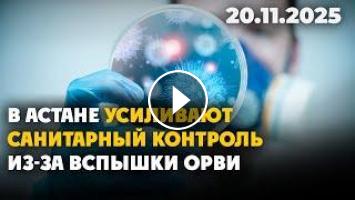

Арнаға тіркел / Подпишись на канал: https://www.youtube.com/@UCqzhjBGNNwAIOH4u0YlJ6NA
Ведущий: Алмас Ашим - https://www.instagram.com/almasashim
Смерть на производстве
В Северо-Казахстанской области работница элеватора утонула в зерне после падения с 30-метровой высоты. Возбуждено уголовное дело.
«Спасаем жизни, но сами на грани»
Фельдшеры Темиртау жалуются на низкую зарплату и высокую нагрузку. Как работает скорая помощь в таких условиях — расскажем в выпуске.
Переходят на удалённую учёбу
В семи регионах Казахстана школьников частично перевели на онлайн-обучение. Причиной стало увеличение случаев заболевания гриппом.
Запрет для пранкеров и коучей
В Казахстане предлагают ограничить фото- и видеосъёмку, чтобы пресечь выходки пранкеров. Под ограничения могут попасть и коучи, раздающие «жизненные советы» в соцсетях.
Юный маэстро и его оркестр
В одном из детских садов Актау работает уникальный оркестр, которым управляет самый юный дирижёр страны. Маленьким музыкантам всего четыре–пять лет, но они уже успели завоевать награды.
---------------------------------------------
Официальный сайт «Седьмого канала» https://tv7.kz/ru/
Instagram: https://www.instagram.com/tv7_kz/
TikTok: https://www.tiktok.com/@tv7_kz
Facebook: https://www.facebook.com/tv7kz/
Telegram: https://t.me/tv7_kaz
#Казахстан #НовостиКЗ #СКО #Темиртау #ОнлайнОбучение #Грипп #Пранкеры #Коучи #Актау #ДетскийОркестр
Ведущий: Алмас Ашим - https://www.instagram.com/almasashim
Смерть на производстве
В Северо-Казахстанской области работница элеватора утонула в зерне после падения с 30-метровой высоты. Возбуждено уголовное дело.
«Спасаем жизни, но сами на грани»
Фельдшеры Темиртау жалуются на низкую зарплату и высокую нагрузку. Как работает скорая помощь в таких условиях — расскажем в выпуске.
Переходят на удалённую учёбу
В семи регионах Казахстана школьников частично перевели на онлайн-обучение. Причиной стало увеличение случаев заболевания гриппом.
Запрет для пранкеров и коучей
В Казахстане предлагают ограничить фото- и видеосъёмку, чтобы пресечь выходки пранкеров. Под ограничения могут попасть и коучи, раздающие «жизненные советы» в соцсетях.
Юный маэстро и его оркестр
В одном из детских садов Актау работает уникальный оркестр, которым управляет самый юный дирижёр страны. Маленьким музыкантам всего четыре–пять лет, но они уже успели завоевать награды.
---------------------------------------------
Официальный сайт «Седьмого канала» https://tv7.kz/ru/
Instagram: https://www.instagram.com/tv7_kz/
TikTok: https://www.tiktok.com/@tv7_kz
Facebook: https://www.facebook.com/tv7kz/
Telegram: https://t.me/tv7_kaz
#Казахстан #НовостиКЗ #СКО #Темиртау #ОнлайнОбучение #Грипп #Пранкеры #Коучи #Актау #ДетскийОркестр
- Категория
- Актау Мангистауская область
Комментариев нет.

ПЕРЕЙТИ НА МОБИЛЬНУЮ ВЕРСИЮ САЙТА
ПЕРЕЙТИ НА МОБИЛЬНУЮ ВЕРСИЮ САЙТА